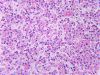

|

Thyroid gland and parathyroid gland (labels) - histology slide
|
|

Thyroid and parathyroid gland (labels) - histology slide
|
|

Thyroid and parathyroid - histology slide
|
|

Thyroid and parathyroid (labels) - histology slide
|
|

Thyroid and parathyroid (labels) - histology slide
|
|

Thyroid and parathyroid glands (labels) - histology slide
|
|

Parathyroid gland and thyroid gland- histology slide
|
|

Parathyroid gland - histology slide
|
|

Parathyroid gland - histology slide
|
|

Parathyroid gland - histology slide
|
|

Parathyroid gland - histology slide
|
|
Parathyroid gland - histology slide
|
|
|